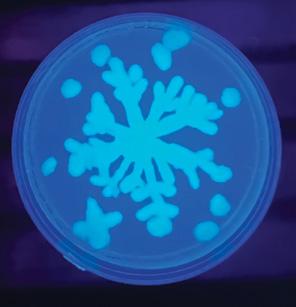

![]()


Dr. John J. Della Croce ‘73 will send the Class of 2025 into the future with words of inspiration and wisdom at MMI’s 133rd Commencement Ceremony in May. Dr. Della Croce is not only an MMI graduate but also a longstanding member of the Freeland community who’s helped improve the dental health of countless area residents.
Dr. Della Croce’s connection to MMI spans generations, with his family’s ties to the school reaching back to the early 1900s. His grandfather, Dr. Joseph M. Della Croce, graduated in 1921, followed by his father, Dr. John B. Della Croce ’47, both attending when MMI was an all-boys school. When Dr. Della Croce enrolled, he was part of MMI’s first co-ed classes, experiencing a new era of the school’s history. The family legacy continued with his daughter, Melissa, who became an MMI graduate in 1998.
During his time at MMI, one moment shines brighter than all the rest for Dr. Della Croce: being a part of the basketball
team that won the Class C State Championship on March 24, 1973. This was the first year that PIAA allowed private and parochial schools to compete. In a stunning victory over Allegheny-Clarion Valley, the Preppers made history as the first-ever private school to win a state championship and as the students who secured MMI’s first and only state championship in a team sport.
It wasn’t all play for Dr. Della Croce though. The rigorous curriculum and high standards at MMI prepared Dr. Della Croce for enduring success in his post-secondary education. Out of the 175 students that entered his King’s College
Dear MMI Community,
As we step into a new year, I hope this message finds you well and looking forward to the opportunities ahead. While winter surrounds us, the warmth of the MMI spirit continues to shine through in all we do. Since our last newsletter, there have been many exciting moments at MMI. Our basketball season is in full swing, and our athletes are competing with skill and determination. The energy at each game is incredible, fueled by the support of our Prepper fans and cheerleaders. Watching our students give their all on the court is always a source of pride and joy.

In November, we honored our founders, Sophia and Eckley Coxe, in a meaningful ceremony at St. James Episcopal Church. Our senior class officers laid a wreath at their gravesites, paying tribute to their legacy. Afterward, our seniors visited the Coxe Family homestead, deepening their understanding of the history and generosity that continue to shape MMI. Thanksgiving brought our community together for a special meal prepared by our talented Chef and her team, topped off with a sweet treat from our Parents Association. As part of our Founders Day traditions, we also welcomed back our younger alumni for a luncheon, giving them a chance to reconnect with faculty and share stories with our current senior class.
December was filled with activity, from athletic competitions to festive celebrations. Our Global Holiday Arts Celebration showcased the musical and artistic talents of our students, and Holiday Theme Week brought an extra dose of joy to campus before we embraced the two-week holiday break.
Looking ahead, spring promises to be just as exciting. We’re eagerly anticipating outdoor athletics, retirement celebrations, academic competitions, and milestone events like Prom and Graduation. One date we hope you’ll save is May 7, our annual Day of Giving, when we’ll come together to celebrate and support the future of MMI.
As we look to the future, we are always eager to welcome new students into the MMI community. If you know a family who might be interested in an MMI education, please encourage them to reach out to our Admissions Office. We would love the opportunity to introduce them to our school and show them all that MMI has to offer.
I am grateful for the dedication of our entire MMI community and encourage you to visit us in Freeland to see firsthand the achievements and opportunities that make our school so special.
Warmly,

Theresa Long Head of School
William A. Shergalis, Ph.D. ‘58 President Emeritus Joseph
Biology program, only five would go on to attend medical or dental school—with Jack being one of those select few. He credits his time at MMI for giving him the circle of friends, work ethic, and perspective he needed to excel in his undergraduate degree.
MMI also fostered the motivations and skills that inspired him to pursue a career in dentistry. Growing up, Dr. Della Croce had a keen interest in two very different fields of study: art and science. He views dentistry as a balanced combination of aesthetics, cosmetics, and scientific inquiry that offers the chance to help others, the freedom to work on his passions, and autonomy in professional and personal decisions.
Dr. Della Croce’s commitment to dentistry has earned him widespread recognition in the medical community, including: a Fellowship (FAGD) and Mastership (MAGD) at the Pennsylvania Academy of General Dentistry; terms as President of the Hazleton Area Dental Society and the Pennsylvania Academy of General Dentistry; fellowships at the American College of Dentists, the International College of Dentists, and the Pierre Fauchard Academy; and a mentorship role at the Temple University School of Dentistry.
He now practices dentistry alongside his daughter, Dr. Melissa B. Della Croce ‘98. As a practice, Della Croce Dental Care is committed to continuing education for both their dentists and support staff. This family clinic is coming up on their 100-year anniversary, and Melissa is all set to carry the torch into the next generation of care. To thrive for as long as this practice has is a true testament to how the Della Croces take care of their staff, treat their patients, and value the Freeland community.

of School
Jim Lundy
Dr. Terry Truitt
Dr. Jack Della Croce
and President Emeritus Joseph Rudawski at last year’s celebration of the 50th Anniversary of MMI’s State Championship in Boys Basketball.
Alongside working with Melissa, Dr. Della Croce also enjoys spending quality time with his wife, Marybeth, who he started dating in 1969 while he was at MMI. They have two other children—one son who followed in his father’s footsteps to become a dentist and another who followed his artistic side to become a photographer. As parents, Jack and Marybeth valued choices for their children: no matter what path they pursued, they encouraged their children to work hard, learn the core curriculums of math and science, and not back away from their passions when the world tried to convince them otherwise.
Dr. Della Croce hopes his graduation speech will have as positive of an impact on the MMI community as the School did on him. We look forward to hearing his moving words in the Founders Day Address come Commencement Day!
Senior Mary Kate Kupsky will continue her academic and athletic career in swimming at Tulane University as a member of the Green Wave. Mary Kate has been an outstanding athlete at MMI, winning the silver medal in the 500m Freestyle and the 200m IM in the District 2 Championships in 2024. At the PIAA State Championships, Mary Kate was 5th in the 500 Free and 8th in the 200 IM en route to being named a Wyoming Valley Conference First-Team All-Star. Mary Kate also participates in crosscountry at MMI, took home a bronze at the District Championships, and placed 36th out of 247 runners at this year’s PIAA Class 1A State Championship in Hershey.



Eighty students from MMI Preparatory School competed in the Future Business Leaders of America (FBLA) Regional competition on Monday, January 13, at the Woodlands Resorts in WilkesBarre. The event included business meetings, a luncheon, and a series of competitions as students vied for a spot at the Pennsylvania FBLA State Leadership Conference.
MMI had an outstanding showing, with 54 of the 80 students advancing to the state competition in Hershey, PA, which will take place from Sunday, April 6 to Wednesday, April 10.
“This achievement is a testament to the dedication, critical thinking, and leadership skills of our students,” said MMI Head of School Theresa Long. “We are incredibly proud of their success and look forward to seeing them represent MMI at the state level.”
MMI’s FBLA Advisor Katherine Zucco echoed this sentiment, emphasizing the significance of the competition. “FBLA provides students with invaluable real-world business experience, helping them develop the confidence and skills they need for future success. Our students worked hard to prepare, and their results speak volumes about their commitment and talent.”
The following students, who will compete in the state competition, placed at the Regional event as follows:
First Place: Sophomores Yoreimy Aponte and Amanda Stoffa – Social Media Strategies; senior Willa Bartholomew – Social Media Strategies; sophomores Philip Benyo and Ian Composto – Intro to Business Presentation; juniors Sam Gatts and Mehak Manzoor – Business Management; senior Diane Kim – Public Speaking; and senior Kendall Orozco – International Business.
Second Place: Juniors Hasan Arain, Jozef Doviciak, and Rishi Patel – Banking & Financial Management; sophomore Katelyn Gera – Intro to Business Communication; senior Brayden Harleman –International Business; senior Gracie Magula –Business Communication; freshman Calli Mason – Intro to FBLA; sophomore Ali Mehran – Intro to Information Technology; freshman Thomas Pantages – Intro to Marketing Concepts; freshman Andrew Pedri – Intro to Business Procedures; senior Hayden Schwabe – Future Business Leader; senior Colin Woolnough – Cyber Security; and senior Winni Zheng – Graphic Design.
Third Place: Senior Eve Corazza – Organizational Leadership; senior Dante DeStefano – Personal Finance; freshman Jack Farrell – Intro to Marketing Concepts; juniors JT Ferry, Joe Mayernik, and David Yamulla –Business Management; junior Adam Frask – Sales Presentation; Ben Gombeda, Christian Schultz, and Jayden Unger – International Business; senior Thomas Horvat – Financial Math; seniors Aiden Hosier, Nick Pantages, and Evan Pedri –Hospitality & Event Management; junior Cassidy
McDermott – Business Communication; freshman Shreeya Parikh – Intro to Business Concepts; freshman Justin Park – Client Service; and junior Arushi Solgama – Human Resource Management.
Fourth Place: Junior Cedrah Abdulrahman –Marketing; senior Lydia Chen – Advertising; senior Alexander Composto – Economics; freshman Patrick Moore – Intro to Business Procedures; junior Sharan Parikh – Financial Math; senior Joshua Witner – Agribusiness.
Fifth Place: Sophomore Maximus Bleiler – Intro to
Business Procedures and sophomore Kenedy Lutz – Intro to Business Communication.
Sixth Place: Junior Alexis Bleiler – Human Resource Management; juniors Gabe Horvath and Caleb Skuba – Hospitality & Event Management; and junior Yeleiny Panigua – Journalism.
Senior Isabelle Wells also advanced to the State Leadership Conference based on her work in the state-only Future Business Educator event, and senior Kiyan Paknezhad also moved on for his work in the state-only Electronic Career Portfolio event.
MMI Head of School Mrs. Theresa Long is pleased to announce The Dr. Philip A. McHale ’58 and Ms. Linda Tishko Scholarship for College Credit Opportunities, a one-time, donor-funded initiative that will reduce 30% of the per-credit cost for eligible students participating in the Pre-College Credit program at Lackawanna College this spring.
Through this program, MMI students have the flexibility to take classes online, attend courses at the Lackawanna College Hazleton Center, or participate in concurrent classes held at MMI Preparatory School to earn college credits. The collaboration aims to save students time and money toward their higher education goals, gain exposure to college-level coursework, review pathways to career-focused programs, and explore fields of study before committing to a major.
Currently, juniors and seniors can choose between nine different concurrent enrollment courses. Additionally, students in 10th grade can select dual enrollment tracks which gives them the opportunity to earn an associate’s degree while still enrolled at MMI.
Mrs. Long was excited about the scholarship, saying, “We are grateful for the wonderful
contribution from Dr. McHale and Ms. Tishko. With this scholarship, we’re excited to provide more students with the opportunity to experience college courses, preparing them for whichever path they choose after graduation. We can’t thank Dr. McHale and Ms. Tishko enough.”
“We are proud to support this program and emphasize the power of collaboration between MMI and Lackawanna College,” said Dr. Philip A. McHale ’58. “By working together, we’re creating meaningful opportunities for students to experience college-level coursework, explore their interests, and build a strong foundation for their future. I hope this initiative inspires even more partnerships that benefit our students and their educational journeys.”

Prospective and current students and families can learn more about MMI’s and Lackawanna College’s Pre-College Credit program by visiting www.mmiprep.org, contacting Dr. Tammy M. Chrin, MMI’s Director of College Counseling, at (570) 636-1108 x169 or tchrin@mmiprep.org, or visiting MMI at the upcoming Discover MMI event on March 26.
More information can be found about those events at www.mmiprep.org/discover-mmi.
Ms. Linda Tishko and Dr. Philip A. McHale ’58

What makes a “good” teacher? For Mrs. Donna Titus’ students, it might be her superhero posters, pop culture references, or lessons steeped in Greek mythology and Jungian archetypes. But for Mrs. Titus herself, the answer is simple: Being a good teacher means loving what she does.
As MMI’s longest-tenured educator and the Associate Dean for juniors and seniors, Mrs. Titus has created a legacy of learning, laughter, and life lessons. Mrs. Titus’ passion for teaching spans some 45 years, starting shortly after her own college graduation. From her first day teaching at MMI, she knew the school was something special. “The biggest thing was the fact that you could really teach,” she recalls.
And teach she did. Discussions in her English classes spanned from ancient mythology, to films and graphic novels, to the Bible as a literary work, inspiring students to think critically and creatively. Beyond the classroom, she mentored students and colleagues, oversaw numerous Open House projects, and advised a variety of clubs, including the National Honor Society, leaving an indelible mark on both MMI’s students, faculty, and programs.
Mrs. Titus’ tenure also witnessed transformations in MMI itself. Besides visible campus expansions, she takes pride in how the school deepened its roots with the greater Hazleton community. A particularly meaningful part of that journey was seeing her three children graduate from MMI in the early 2000s. Balancing the roles of teacher, wife, and mother had its challenges, but she recalls it as “one of the most enriching times” of her life. She credits much of her success to her husband, Albert, saying, “Without his support, I would not have been as successful.”
Still, teaching was not without its difficulties. Of the pandemic years, Mrs. Titus vividly remembers the muffled voices of masked students and the technical difficulties of remote learning. Yet even in adversity,
she found moments of levity. “Kids being kids,” she said with a laugh, “They’d be in their own room, in their own home, and they’d still raise their hand to ask me if they could go to the bathroom. I got a kick out of that.”
Equally precious to her are the genuine companionships built with coworkers. In particular, she fondly recalls being the Advisor for the Class of 1995 with her dear friend and colleague, the late Señor Dennis Clarke, and the seniors’ trip playing paintball. “That kind of bonding was special,” she said with a smile.
With retirement on the horizon, Mrs. Titus is excited to spend more time with family, volunteer at the local animal shelter, and remain active in her church. She also looks forward to enjoying life with her three dogs, her flock of chickens, and her three roosters.
To the Class of 2025, Mrs. Titus offers some parting words of wisdom: “I’ve always been a stickler for trying to find what will make you get out of bed in the morning,” she says. “Look for the activity, the profession, the job that will make you enjoy it every day.”
Thank you, Mrs. Titus, for your dedication to MMI and our students. Your legacy will continue to inspire generations to come — and you’ll always be our Captain.


One of MMI’s most respected educators, science teacher Mr. Tim Garvey, is retiring at the end of the 2024-25 school year. Mr. Garvey had an admirable career both before and during MMI, and we thank him for his many years of dedication to our community.
When Mr. Garvey joined MMI, he already had 30 years of experience as a teacher, plus several more in the FBI firearms lab. Needless to say, he was knowledgeable. He was also in tune with students’ needs and committed to education from day one— and that’s how he’s remained for more than a decade at MMI.
Mr. Garvey admits that three decades of experience isn’t always an asset when searching for a new teaching job. When he arrived at MMI, however, he found a place where his skills and intelligence could inspire budding minds—and MMI found the perfect teacher to mold our next generation of burgeoning scientists.
Mr. Garvey taught many lessons during his time at MMI. As he gets ready to retire, he’ll be remembered for teaching high school physics, high school AP Physics, and seventh-grade science.
But Mr. Garvey wasn’t only an educator during his time at MMI. He’s likewise been a leader outside of the classroom as a cross country, boys’ tennis, and girls’ tennis coach.
Mr. Garvey took similar approaches to both teaching and coaching while at MMI, stating: “I always felt if you have a teacher who’s enthused, who you can see loves what they’re doing, the students might listen a little bit more.” And listen, they did.
Mr. Garvey’s unique perspective on education was reflected in his passionate, dynamic teaching style— something that MMI fostered by offering both freedom and flexibility. Mr. Garvey recalls being able to teach the subjects he loves in the ways he saw fit. Every other class was a lab or activity, creating hands-on experiences his students will surely miss.
While Mr. Garvey will likewise miss his students and MMI, he is looking forward to retirement. He’s excited to have more time to pursue his passions outside of work, including volunteering with Meals on Wheels and helping adults with special needs; spending time with his grandchild, camping with his wife, and gardening. He might even get a passport and fly for the first time in his life.
When asked if Mr. Garvey had any final words of encouragement for this year’s graduating class, he said, “You can’t really be wrong if you bring your best and bring what you are wherever you go. Be who you are, do the best you can, and you’re a success. Success is about being the best you can and sharing that with other people.”
Thank you, Mr. Garvey for inspiring countless students with your love of teaching. We’ll miss you, but we’re so excited to see what you’ll do, and where you’ll go, next!



MMI Preparatory School’s celebrated culinary conductor, Chef Teresa Kairewich, is hanging up her apron after the 2024-25 school year. For more than a decade at MMI, she’s prepared the meals that boost our students’ brainpower and fuel their ability to learn.
Before Chef Kairewich joined the School, there was no full-time Chef on staff at MMI. In those days, a local area restaurant provided hot lunches, or students packed their lunches, or went off-campus to eat. Then, Chef Kairewich joined the family, introducing healthy, hearty in-house meals that everyone could enjoy. She cooks from scratch and takes pride in expanding students’ culinary horizons.
With wholesome ingredients — and a little bit of salt, pepper, and olive oil — she tries to elevate underappreciated foods and turns them into schoolwide favorites.
Chef Kairewich keeps the menu familiar and appetizing at MMI by featuring a meticulously planned rotation of options like Caesar salad, stuffed pepper soup, parmesan-crusted chicken, ham and cheese sandwiches, chicken nuggets, grilled cheese, fruit-topped waffles, and macaroni and cheese with stewed tomatoes. Every school year brings Chef Kairewich the new challenge of what to put on the menu that will leave the students asking for seconds.
Most of her proudest moments at MMI have been centered around students’ favorite meals: an alum home on winter break calling Chef Kairewich and asking her to make her mac and cheese, a student shouting out Chef’s penne alfredo in his graduation speech, and a parent telling her that their child never ate broccoli before coming to MMI.
As she enters this new chapter of life, Chef looks forward to spending more time with her grandchildren, boating with her husband, and fostering animals. She will dearly miss the MMI community—she’s always appreciated how the school empowers staff to explore their interests, grow, and improve. Chef Kairewich crafted her own culinary path at MMI, and we thank her for all the delicious developments we got to taste along the way.
Thank you to everyone who joined us for MMI’s Mid-Winter Social at Valley Country Club on Friday, February 7! From yummy appetizers and signature MMI Margaritas to lively conversations, it was the perfect way to shake off the winter blues and reconnect our MMI community.






MMI Preparatory School held its Poetry Out Loud competition on Friday, October 25. Six students throughout the freshmen and senior classes competed, including sophomore Christina Chrin, senior Diane Kim, senior Kendall Orozco, junior Ava Genetti, sophomore Arham Mehran, and freshman Evan Polanco. Christina Chrin was announced as the winner on Monday, October 28.
Christina Chrin represented MMI at the regional competition, where she competed against students throughout Luzerne, Lackawanna, Northwestern Pike, Susquehanna, Wayne, and Eastern Wyoming counties. Christina placed third at the regional competition held at Luzerne County Community College on Tuesday, December 10. Christina recited three poems in the regional competition: “Beautiful Wreckage” by W.D. Ehrhart, “Breakfast” by Mary Lamb, and “Confessions” by Robert Browning.
“Poetry Out Loud provides students with a remarkable opportunity to explore the power of language and performance,” said Theresa Long, MMI’s Head of School. “We are so proud of Christina’s success and how beautifully she represented MMI at the regional competition.”
“Christina’s dedication and poise in delivering such complex and emotionally resonant poems was excellent,” said Dr. Jeremy Davidheiser, one of the two advisors for the competition, along with Mrs. Jennifer Novotney. “Tina should be exceptionally proud of her performance, especially as a first-time performer and a sophomore! Her achievement at
the regional level is a testament to her hard work and passion for literature.”
Poetry Out Loud is an annual event where students across the country as well as American Samoa, Guam, Puerto Rico, and the U.S. Virgin Islands are tested in dynamic poetry recitation. The program is designed to improve public speaking skills, build confidence, and teach students about literary history and contemporary life. Since 2005, more than 4 million students, 81,000 teachers, and 20,000 schools have participated in Poetry Out Loud.
Congratulations to Christina and all of the students who competed in this year’s competition!
MMI Preparatory School sophomore
Christina Chrin pictured with advisor Dr. Jeremy Davidheiser.

Dr. Cornelius Coll ’60 and Mrs. Anne Coll provided a classroom set of TI-84 Plus CE graphing calculators for Mr. Tony Bianco’s Calculus class. These advanced calculators, essential for math and science learning, offer vibrant graphing, symbol recognition, and exam-approved functionality, helping students develop critical problem-solving skills.

The Barbara L. Sowers and Joseph A. Turri ’45 Music, Drama, and Fine Arts Endowed Fund of the Luzerne Foundation enabled the purchase of a pottery wheel and an Artograph Futura Light Table. The pottery wheel allows students to explore handson ceramic artistry, while the light table provides an illuminated workspace ideal for animators, illustrators, and designers. It is also excellent for calligraphy, drafting, scrapbooking, and other creative applications. These tools expand our arts curriculum, inspiring creativity and innovation in the classroom.

An anonymous donor funded the purchase of Wolfram Software to enhance MMI’s STEM programs. This powerful computational tool supports mathematics, science, and engineering through dynamic visualization, live computation, and an interactive notebook system, giving students access to industry-standard technology.
The Hersker Foundation funded the purchase of 125 brand-new music chairs in late December. These chairs are more than just seats—they’re a foundation for our students’ growth in musicianship, posture, and performance quality. From band and chorus to our Prepper Playhouse productions, these types of enhancements will inspire every note sung, played, and performed.

chairs, a gift from Mr. John Hersker ’76 through his Foundation, supporting our students’ growth in the performing arts.

A generous donation from The Hersker Foundation supported the FBLA Club’s field trip to Cinema & Drafthouse, where students enjoyed lunch and a movie, followed by an in-depth discussion at school. The Hersker Foundation and the Orlando Family Foundation have made gifts that fund student participation in Regional and State FBLA competitions.
The Dr. Philip A. McHale ’58 and Ms. Linda Tishko Scholarship for College Credit Opportunities was established through their generous donation. This scholarship will reduce 30% of the per-credit cost for eligible students in MMI’s Pre-College Credit program at Lackawanna College this spring. This initiative allows MMI students to take online, in-person, or concurrent college courses at MMI, offering a cost-effective way to earn college credits, explore career paths, and gain experience with college-level coursework. Juniors and
seniors can choose from nine concurrent enrollment courses, while 10th graders can pursue dual enrollment tracks leading to an associate’s degree.
the memory of their daughter by Mr. and Mrs. Joseph Yuscavage.

President Emeritus Bill Shergalis ’58 and Mrs. Miki Shergalis also gave a gift toward the upkeep of Sarah’s Garden, a living memorial garden in the Kahler Courtyard created to honor Sarah Jane Yuscavage ’04. On January 15, 2004, just four months shy of her graduation from MMI, Sarah passed away as a result of injuries sustained in a car accident. She had been selected as a nominee to continue her education at the United States Military Academy at West Point. While at MMI, Sarah was a member of the Drama Club, Interact Club, Amnesty International, National Honor Society, Spanish National Honor Society, as well as the softball, tennis, and basketball teams. She was an active member of St. Jude’s Parish, where she volunteered for many activities including as a Bible School student aide, pre-school volunteer, and a member of PennDOT’s Highway Clean-Up program. She was the co-captain of MMI’s Relay For Life team, and served on the Helping Hands Society and Serrento Gardens Student Boards. The Sarah Jane Yuscavage ’04 Endowed Scholarship was established in 2007 to support current MMI students and to honor
A special thank you to the Beerbower family for their generous donation of a Duncan Ceramic Kiln to the MMI Visual Art Program this fall. With this kiln, students can bring their artistic visions to life, experiment with various glazing techniques, and gain hands-on experience with the ceramic process. We are deeply grateful for their support!
President Emeritus Bill Shergalis ’58 and his wife, Miki, generously supported our winter athletics program, with a recent gift towards basketball. The donation enabled the purchase a 70-inch flat screen TV and a rolling cart to utilize during film breakdown for our teams. Thank you!

Four MMI seniors—Corey Buchman, Diane Kim, Isabelle Wells, and Winni Zheng—have been honored by The College Board’s National First-Generation Recognition Program. This distinction highlights high-achieving, underrepresented students who have excelled academically. To qualify, students must have taken the PSAT/NMSQT, PSAT 10, or AP Exams and met specific academic criteria, including scoring in the top 10% of test takers in their state or earning a 3+ on two or more AP exams in 9th or 10th grade. They must also maintain a cumulative GPA of B+ or higher.
Additionally, Diane Kim and Winni Zheng received recognition from the National Rural and Small Town Recognition Program, one of five national recognition programs run by The College Board. MMI has a longstanding tradition of supporting first-generation students in their pursuit of higher education. Founded by Eckley B. Coxe to provide educational opportunities to those who otherwise might not have them, MMI continues to uphold that mission today.
“Every day, MMI students embody the spirit of our founder’s mission. I’m proud of Corey, Diane, Isabelle, and Winni for receiving this recognition and showcasing the true MMI spirit,” said Theresa Long, Head of School.


MMI students, faculty, staff, and alumni came together to celebrate Founders Day, a cherished tradition that honors the legacy of Eckley Brinton Coxe and his wife, Sophia Georgianna Coxe. The event, held on November 26-27, provided a meaningful opportunity for the school community to reflect on the Coxes’ vision and lasting contributions to MMI and the Hazleton area.
On Tuesday, November 26, the day began with a graveside tribute at St. James Episcopal Church, where senior class officers laid a wreath at the Coxes’ final resting place. Mrs. Donna Titus, Associate Dean and English Department Chair, shared a few words in remembrance of the school’s founders. Following the ceremony, seniors toured the historic Coxe home and enjoyed refreshments before returning to campus, where they collaborated with underclassmen to present a play and activities showcasing the history of MMI’s founding.
Reflecting on the occasion, Head of School
Theresa Long remarked, “Our history is both deep and extraordinary. Honoring Eckley and Sophia Coxe gives students a meaningful chance to


express gratitude for the vision and determination of the Coxe family, which shaped the School as we know it today.”
The celebration continued with an all-school holiday luncheon, marking the last day of classes before the Thanksgiving break.
The following day, November 27, MMI welcomed alumni from the Classes of 2014-2024 for the Founders Day Young Alumni Luncheon, where graduates reconnected with former classmates and faculty over good food and great memories. Special thanks to the senior class for joining the festivities on their day off, and to all the alumni who returned—it’s always a pleasure to have you back on campus!
The story of Eckley and Sophia Coxe is one of innovation, philanthropy, and dedication to education. A graduate of the University of Pennsylvania, Eckley pursued advanced studies in Paris and Germany before returning to the U.S. in 1864 to establish Coxe Brothers & Co. His leadership in the coal industry led to the consolidation of more




than 35,000 acres of coalfields, revolutionizing mining operations in Northeastern Pennsylvania. But perhaps his greatest legacy was the establishment of the Mining and Mechanical Institute—today’s MMI.
Sophia Coxe, affectionately known as the “Angel of the Anthracite,” was a devoted philanthropist whose charitable work left a lasting impact on the community. She established the first hospital in Drifton, helped found St. James Episcopal Church in 1884, and dedicated four decades to teaching Sunday school. Her commitment to MMI was unwavering—
on her 85th birthday and final Thanksgiving in 1925, despite declining health, she attended the dedication of the school’s new gymnasium, determined to see its completion. She passed away four months later in March 1926 and was laid to rest beside her husband at St. James Episcopal Church.
Through the annual Founders Day celebration, MMI students continue to honor the Coxes’ enduring legacy of education, service, and community—a tradition that remains at the heart of the school’s mission today.

MMI Preparatory School Head of School
Theresa Long announced that senior Kendall Orozco was selected as a Commended Scholar in the 2024 National Merit Scholarship Program. A letter of commendation from the National Merit Scholarship Corp., which conducts the program, will be presented to the scholastically talented senior.
“We are incredibly proud of Kendall and all she has achieved,” said Long. “Congratulations to her on being named a National Merit Scholarship Commended Student. At MMI, our students’ dedication and effort within our rigorous curriculum are consistently recognized by the National Merit Scholarship Program, and Kendall’s honor is a testament to that.”
About 34,000 commended students throughout the nation are being recognized for their exceptional academic promise. Although they will not continue in the 2024 competition for National Merit Scholarship

Awards, commended students place among the top 50,000 students who entered the 2024 competition by taking the 2023 Preliminary SAT/National Merit Scholarship Qualifying Test.
According to an NMSC news release, “Those being named commended students have demonstrated outstanding potential for academic success. These students represent a valuable national resource; recognizing their accomplishments, as well as the key role their schools play in their academic development, is vital to the advancement of educational excellence in our nation. We hope that this recognition will help broaden their educational opportunities and encourage them as they continue to pursue their pursuit of academic success.”
Kendall Orozco, who was selected as a Commended Scholar in the 2024 National Merit Scholarship Program. Kendall was one of 34,000 students across the nation that was recognized for her academic promise.

MMI hosted its first-ever Global Holiday Arts Celebration on December 13, bringing together visual arts, music, and world languages in a vibrant showcase of student talent. Upon entry to MMI, visitors explored an impressive collection of global-inspired artwork from each grade level, featuring European landscapes, Russian Kandinsky circles, African animals, Iroquois creation stories, Chinese vases, alebrijes, Eiffel Tower pointillism, and more. Every piece reflected the students’ artistic growth under the guidance of Dr. Lisa Ferry and Mrs. Laurie Mele.
The celebration featured outstanding musical performances by the MMI Chorus and Concert Band, captivating the audience with beautiful melodies. The Language Department delighted attendees with multilingual songs, including a lively rendition of Brother John in French, Spanish, and Chinese. The Black Diamond Chorale and Select Chorus added to the festive spirit with performances that truly brought the holiday season to life.



“The Global Holiday Arts Celebration was a wonderful showcase of our students’ creativity and cultural appreciation,” said Joanne Oakum, Creative and Performing Arts Department Chair. “At a time when many schools are scaling back arts programs, MMI continues to invest in music and the visual arts, providing students with opportunities to express themselves, explore different cultures, and develop their talents in meaningful ways.”
Special thanks to Music Director Ms. Jennifer Gerhard, World Language Instructors Señorita Syra Dewar, Ms. Natasha Keyser, and Mrs. Christina Spencer, along with the entire Creative and Performing Arts Department, for making this inaugural event such a success. MMI looks forward to building on this tradition and continuing to expand arts education for its students.








The MMI Parents Association put together a great fall celebration on October 31 in the Kahler Courtyard. Activities included pumpkin painting, ping pong, corn hole, giant Jenga, cup pong, Pictionary, Minute-to-Win-it games, and, of course, plenty of Halloween candy! Two days later, the Parents Association hosted the annual Harvest Dance for MMI Upper School students and their guests. Thank you to our volunteers who worked their magic, turning the Coxe Commons and the MMI Cafeteria into a cozy, autumn-inspired space perfect for celebrating the season.

Ms. Mara Zumchak’s 7th grade advisory won the Operation CAN DO drive competition. MMI’s representatives on the CAN DO, Inc. Student Action Committee (SAC) are (left to right): Hayden Schwabe ’25, Ava Genetti ’26, and Committee Chair Alex Composto ’25. This initiative, organized by the SAC and the Freeland American Legion Post 473, helped send a bit of holiday cheer to our military heroes.
On election day, six MMI seniors served as Luzerne County presidential election poll workers, making a difference throughout the County. Hayden Schwabe, Evan Pedri, Aiden Hosier, Isaiah Perez-Serrano, Corey Buchman, and Colin Woolnough (left to right) embraced this important civic duty, and we are thankful to Mrs. Grete Floryshak ’92 for setting up this opportunity.



The Students of the Quarter were Mason Makoweicz ’31, Ivan Ortiz ’30, Marlow Basalyga ’29, Arianna Larsen ’28, Gavyn Corchado ’27, Ava Genetti ’26, and Diane Kim ’25. These exceptional students were chosen by their teachers for their outstanding character and helpfulness during the first marking period. On November 13, these students enjoyed a special lunch, courtesy of Head of School Mrs. Theresa Long. A huge thank you to Mrs. Long for her continued leadership and encouragement, and to our students for their contributions to our school community!

On November 13, Lehigh Valley HospitalHazleton held an after-school training session at MMI for students in grades 10-12 interested in American Heart Association CPR certification.
MMI has been recognized by the College Board on their 2024 AP School Honor Roll with a “Gold with Access” award! This distinction highlights schools with AP programs that deliver great results and prioritize equitable access for all students. Only 32% of eligible schools nationwide make the Honor Roll; of those, just 7% receive the Gold Award; even fewer – about 1/3 of that 32% – also earn the Access Award for fostering equity in advanced coursework.


The MMI Chinese, Spanish, and French classes sponsored their International Pot Luck Dinner on November 14. The event was a huge success, thanks to the efforts of Mrs. Christina Spencer, Ms. Natasha Keyser, and Señorita Syra Dewar who led the way in organizing a night of delicious food, great company, and cultural celebration.

Parents Association Trivia Night was November 15. It was an evening of fun, competition, and community. Congratulations to our top teams: “We Won’t Come In Third This Time!” for clinching first place (bottom row), The Pocolopes for taking second (middle row), and Sigmas Unite for securing third (top row).

School Resource Officer Mr. Wayne Warner completed the Crisis Management for School-Based Incidents for Key Decision Makers certification this fall. This intensive two-day course provided operational-level training to enhance crisis response, communication, and collaboration for school-based incidents. Mr. Warner also gained additional skills in all-hazards planning, threat assessment, and recovery.
On November 19, Assistant Head of School, Mrs. Marci Hosier, delivered a presentation on “AI (Artificial Intelligence) in Everyday Life” at the Women’s Networking Luncheon hosted by the Greater Hazleton Chamber of Commerce.
Dr. Lisa Ferry, MMI faculty member, successfully defended her doctoral dissertation, “High School Students’ Experiences with a School-Based Meditation Class and the Impact on Their Emotional Wellness and Self-Regulation,” at Wilkes University before Thanksgiving.
Olivia Moore ‘28, took center stage as The Snow Queen in the December 6 production of The Nutcracker by DM Performance Works! A dedicated ballerina for 10 years, Olivia is no stranger to the spotlight. This marks her sixth year performing in The Nutcracker, and she’s danced many magical roles over the years.
On December 5, Alexis Bleiler ’26 (back row, 2nd from left) and her Junior Leadership team hosted a holiday party at the Helping Hands Society as part of their community service project.


Thank you to the MMI Parents Association for a magical treat on December 12! We had reindeer in the Courtyard! Thank you also to Haunt Coffee LLC —a spooky-cool coffee shop and bookstore in Wilkes-Barre owned by Jamie Gatts ’01—for brewing up some holiday cheer with their generous donation of hot chocolate, cupcakes, and Rice Krispie Treats for the students.

MMI took home 5th place in the Greater Hazleton Chamber of Commerce Women’s Networking Holiday Decorating Contest! We’re proud to share our holiday spirit with the community.
Diane Kim ‘25 is advancing to the QuarterFinalist Level of the 2025 Elks MVP Scholarship. The Elks National Foundation will award 500 four-year scholarships to the highest-rated applicants in the 2025 competition and the winners will be announced in April.

In mid-January, 10th grade students interested in the Dual Enrollment/Level Up Program met with Ms. Abbey Judge from Lackawanna College via Zoom to learn how they can earn college credits—and an associate’s degree—while still in high school. This opportunity allows students to explore career pathways, experience college coursework, and save time and money on their higher education journey.


On October 31, our Spanish Class celebrated All-Saints Day with an Empanada and Bake Sale. They sold out of empanadas during the morning break, and also offered walking tacos, brownies with ice cream, and cookies to satisfy everyone’s cravings. These students came in before school to handcraft each empanada under the guidance of Senorita Syra Dewar. The line stretching out into the Coxe Commons said it all—these empanadas were a hit!
In early November, students in Mrs. Shannon Falcheck’s 6th grade science class had the opportunity to look at their own cheek cells under the microscope. Seeing science up close and personal is an amazing way to learn.



Mrs. Katherine Zucco’s 11th and 12th grade World History II students showcased their knowledge of Imperial Asia with an exciting hands-on project in the Coxe Commons. Working in groups, students studied the architectural achievements of the Ming and Manchu Dynasties in China and the Tokugawa Era in Japan. Then, they transformed what they learned into edible “imperial compounds.” Alongside their culinary creations, they presented detailed PowerPoints explaining the political, economic, and military developments of these fascinating periods.

MMI’s 9th grade history students participated in a “book tasting” in the Joseph A. Turri ‘45 Library and Learning Center in mid-November. Mrs. Grete Floryshak ‘92 curated a variety of American history books, which were placed on tables for students to explore. Each student browsed the selection and chose five books to write their first impressions about. From their choices, one book was assigned to each student for a deeper dive.

Mrs. Laurie Mele’s 7th grade art class got inspired by the beauty and diversity of African wildlife. They began to create animal artwork, capturing the essence of these majestic creatures.

Ms. Michele Tyburski’s 8th grade science lab dove into the world of chemical and physical changes, exploring the five key signs of chemical change, especially the formation of precipitates. Students combined liquid chemical compounds, observing firsthand how new substances can emerge.

Mr. Michael Mele’s AP Biology students conducted a lab exploring transformation - a process where genetic material from one organism is inserted into another. In this lab, they worked with a jellyfish gene that makes organisms glow under UV light. When successfully transferred, the bacteria glow. The students got creative, using glowing bacterial cultures to design beautiful patterns and demonstrate how colonies grow where they’re seeded.
On November 19, MMI students had the opportunity to learn about Nurse Anesthesia. Mrs. Debra Minzola, Director of the Geisinger/Bloomsburg Nurse Anesthesia Program, along with her students, visited Mr. Michael Mele’s science classes. Students gained valuable insights into the critical role of a Certified Registered Nurse Anesthetist (CRNA). They participated in interactive activities, including practicing intubation techniques and learning the proper methods for gowning and gloving.
On November 20, in Mr. Tim Garvey’s 11th grade physics class, students learned about weights and measures! Through hands-on experiments with measurements, pulleys, and weights, students explored the principles of dynamic force in action.


MMI 8th grade English students in Ms. Susan Baggs’ class read Julius Caesar aloud on November 25. This interactive approach not only brings Shakespeare to life but also helps students improve their comprehension, public speaking skills, and confidence as they explore meaning behind each line.

Mrs. Melissa Zaroda’s Intro to Circuits & Robots class is making history as the first-ever group to take this exciting new elective at MMI. These 11th and 12th graders are tackling the fundamentals of DC circuits through hands-on learning, including their mid-term project: completing Red Light/Green Light circuits. In this inaugural elective course, students are mastering concepts like voltage, current, and resistance while building circuits, coding in Python, and preparing to integrate their designs into robotic systems.




MMI’s ninth graders took a step back in time at the Gatsby Gala on January 8, hosted by Mrs. Grete Floryshak ‘92 and Mrs. Donna Titus. This event was the grand finale of a unique cross-curricular unit blending English and American History. Through The Great Gatsby, students explored literary themes of the American dream while learning how people chased financial success in the late 19th and early 20th centuries in History class. The celebration featured a luncheon and a special screening of the film adaptation of Fitzgerald’s classic novel. Huge thanks to Dr. Philip A. McHale ’58 and Ms. Linda Tishko, whose Curriculum Collaboration Grant made this interdisciplinary project possible.

On January 19 the Spanish IV class, led by Señorita Syra Dewar, brought the magic of the Feast of the Three Kings to life. Students wrote and performed a play retelling the journey of the Three Kings, sharing this tradition with the entire school. The Spanish II class put their skills to the test by building their own piñatas as part of the celebration. The student body cast their votes, and the winners were, in first place, Peru by Katherine Arias ’27 and Kenedy Lutz ’27, second place was Colombia by Savannah Romero ’27 and Delilah Yatsko ’27, and the third-place piñata was Puerto Rico by Max Bleiler ’27 and Ian Composto ’27.


In early November, 22 seniors in the MMI FBLA Chapter and their Advisor, Mrs. Katherine Zucco, attended the 2024 Pennsylvania State Leadership Workshop (SLW) at the Kalahari Resort. This year’s theme was “All In.” Students attended various workshops, learned from motivational speakers, and participated in several fundraising events for the American Red Cross. Hayden Schwabe ‘25, PA FBLA State President, presided over the SLW with his team of fellow state officers, organized teambuilding exercises, and presented several workshops


Shreeya Parikh ’28 and Gavyn Corchardo ’27 showcased their musical talents at the 2024 Dorothy Sutton Performance Festival, held on November 9 at Lebanon Valley College. This prestigious festival, organized in collaboration with the PA Music Teachers Association, celebrates student musicians invited to perform based on earning “Superior” ratings in both performance and music theory assessments.

The MMI Black Diamond Chorale, under the direction of Ms. Jennifer Gerhard, performed at the Lehigh Valley Health Network Hazleton Community Health Symposium on November 20. The symposium brought together local community partners to discuss topics surrounding the factors that influence health and well-being.


On November 23, MMI competed at the Monroe County Bar Mock Trial Invitational. The competition saw multiple teams from 15 area schools. The 16 students from MMI trialed with poise, preparedness, and great sportsmanship. Thank you to volunteer Attorney Dave Pedri for his support and to Mock Trial Advisors Mrs. Cheryl Bayo and Ms. Mara Zumchak.

MMI’s FBLA students and their advisor Mrs. Katherine Zucco enjoyed a special outing on December 6, sponsored by Mr. John Hersker ‘76. The group visited Cinema and Drafthouse for a screening of the holiday classic It’s a Wonderful Life. Students were warmly welcomed by Mr. Hersker, who shared an insightful introductory presentation about the film, and Ms. Sybil Katona, the theater’s owner.

On December 4, MMI’s Black Diamond Chorale had the honor of performing at the annual CAN DO Community Christmas, bringing holiday cheer to Downtown Hazleton. After the Mayor’s tree lighting ceremony, Chair Alex Composto ’25, Hayden Schwabe ’25, Ava Genetti ’26, and the other members of the CAN DO Student Action Committee hosted the festive event at Christ Lutheran Church.
MMI Interact Club and advisor Ms. Lani Drobnock spent the morning at the Hazleton Integration Project sorting and bagging coats for Hazleton Rotary’s Kidz Coatz project.

On December 6-7, seven of MMI’s talented musicians hit the stage for the Marywood Junior Wind Band Celebration after acing their auditions and earning spots in one of two honor bands. Over the two days, they rehearsed with expert clinicians and joined 250 instrumentalists in grades 7-9 for a performance on Saturday evening.
Our representatives, who are under the direction of Ms. Jennifer Gerhard, were: in the front row Jared Santana ’28 (alto saxophone), Arianna Larsen ’28 (flute), Denna Stellar ’28 (flute), Thomas Rogers ’29 (euphonium), Dillan Garcia ’28 (tenor saxophone) and in the back row, Yaslin Tejeda Nivar ’29 (clarinet) and Evan Polanco ’28 (trumpet).
On December 4, Kendall Orozco ‘25 shared her passion for the ENGin Program with Hazleton Rotary during their weekly lunch meeting. Kendall, who serves as an Ambassador and volunteer with ENGin, spoke about the impact the Program has on bridging language barriers and fostering global connections. ENGin connects English-speaking volunteers with English learners abroad, providing weekly video chat sessions that build language skills and cultural understanding. This initiative has already reached over 48,000 participants.
Pictured with Kendall are Rotary President Alan Whitaker ’83 and Rotary President-Elect Joan Buffington.
On December 8, Tina Chrin ’27 and Madalynn Young ’28 joined Music Director Ms. Jennifer Gerhard at the Krapf & Hughes Funeral Home in Drums for their 2024 Christmas Memorial Service. The trio performed clarinet pieces, offering comfort and reflection to families honoring loved ones lost this year.



The MMI Black Diamond Chorale spread some festive cheer on December 16 with a fun caroling session at the Luzerne County Courthouse. They performed beloved classics like “Jingle Bells” and “Deck the Halls,” along with a playful rendition of “Chipmunk Song” featuring kazoos. The group was warmly greeted by MMI Board Member Mrs. Anne Frey at the Courthouse.
MMI’s National Honor Society volunteered at the Winter Wonderland at the Mohegan Sun Convention Center, hosted by the LuzerneWyoming County Early Intervention Program, Collaborative Autism Movement, and Parenting Autism United. Thank you to Dr. Lisa Ferry and Mrs. Joanne Oakum for chaperoning.





Christina Chrin ‘27 represented MMI at the PMEA District 9 Band Festival at Mountain View High School on January 22-24. Tina completed a successful audition in November to secure her place in the 160-member ensemble, encompassing the best musicians from over 40 schools in Lackawanna, Luzerne, Susquehanna, Wayne, and Wyoming counties. District Band students worked under the baton of guest clinician, Dr. Jason Worzbyt, Director of Bands at Indiana University of Pennsylvania before presenting a public concert to conclude the festival.
The Ski Club is off and running this winter and kicked off its first trip of the year in early January at Montage Mountain. Several students experienced skiing for the very first time, and with the help of chaperone Mrs. Angela Dupuis, they were gliding down the mountain with confidence by the end of the day. We even had a few snowboarders join the action. Dr. Heather Grimm serves as the club’s Advisor.



The Mid School and Upper School Cheer teams made the most of a day off from School on Friday, November 8. With guidance from trainers from the National Cheerleaders Association, Coach Laurie Mele, and volunteer Gavrielle Mele, these athletes mastered new cheers and elevated their stunting techniques.
MMI hosted a Meet the Preppers event on November 25. It was both a celebration of our winter sports teams and a show of community spirit as we raised funds for an MMI family facing the loss of their home in a fire earlier in the month. From the duck toss and bake sale to the many generous donations, everyone came together to make a difference.





Kendall Orozco ’24 and Ava Genetti ’25 were named Citizens’ Voice Girls Tennis All-Stars. Kendall had an impressive season, dominating as one of the top singles players in the Wyoming Valley Conference. Ava posted a 14-0 record at No. 2 singles, going undefeated in the regular season. Ava and Kendall both reached the District quarterfinals in singles and then they teamed up to win two District doubles matches.

On January 3, swimmer Mary Kate Kupsky ‘25 made serious waves at Hazleton Area High School, breaking not one but two pool records! She set a new mark in the 200 IM with a time of 2:07.95 and the 500 Free with a time of 5:07.80. On January 28, she shattered the Hazleton pool record in the 200 free with a time of 1:55.93 and re-broke her own record in the 100 back, touching the wall at 58.93.
The Boys Basketball Team kicked off their season at the Mountain Madness Basketball Tournament at Sullivan County High School. Josef Dovicik ’26 and Jandel Figueroa ’26 were named to the Mountain Madness All-Tournament Team.

MMI proudly hosted two Coaches vs. Cancer games in late January. The Prepper girls took on Nanticoke on January 27, and the boys faced Tunkhannock on January 31. All game ticket and 50/50 raffle proceeds supported MMI’s donation to the American Cancer Society. Coaches vs. Cancer is a nationwide initiative that unites basketball coaches in the fight against cancer.
David Africa ’80 served as a mission partner to the Evangelical Church of Bavaria with the Outreach Foundation to assist and support a church plant of persecuted Christian Diaspora from Iran in 2024. He is also currently serving with the National State Auditors Association (NSAA) planning the 2025 Emerging Leader Conference, as well as serving the National Association of State Auditors, Comptrollers and Treasurers.



On December 14, Morgan Allen ‘21 graduated Summa Cum Laude from Kutztown University with a BS in Fine Art and a minor in Art History.
Diane Arias-Tejada ‘24 couldn’t attend the Founders Day Young Alumni Gathering but, instead spent some time with Mrs. Laurie Mele and Mr. Michael Mele, baking cookies.
Millie Symbula Collins ‘21 graduated from Bloomsburg, a campus of Commonwealth University of Pennsylvania, on December 14. Millie earned her Bachelor’s degree in Early Childhood PK-4 Education, graduating Cum Laude.
On January 17, Lauren Herman ’19 stopped by the School to visit with Mrs. Jennifer Novotney (our Director of Curriculum & Instruction and a published author), who gave her some top-notch advice on a writing project. She also took time to visit with Librarian Kyle Falatko ’18.
Reed Floryshak ‘24 was awarded a Bloomsburg Alumni Legacy Scholarship worth $1,195 for the spring semester. Thanks to the Bloomsburg Alumni Association Board of Directors, students with a Bloomsburg alum as a parent or grandparent get the chance to win this scholarship through a random drawing every November. Reed’s mother, Roxanne, is an alumna from 2001, and he is carrying on the family Husky tradition.

MMI alumna and former Prepper Cross Country standout Brianna Kramer Mills ‘09 has made the Run for the Diamonds in Berwick a Thanksgiving tradition. Traveling 750 miles from her home in Summerville, SC, to her hometown of St. Johns, PA, Brianna competes each year in this iconic 9-mile race. For 16 out of the last 17 years, she has run the race. The first year was with Coach Jon Weaver, his daughter, and MMI teammates, while the last 15 races were with her father, Brian Kramer. The race has become a special event for the family, including a memorable proposal by her now-husband, Nick, at the finish line in 2018! A few days after the race, she spent some time catching up with MMI Cross Country Coach Jon Weaver.

A group of MMI alumni and their families gathered in Boston on November 22 for a mini reunion with faculty members Mrs. Donna Titus, her husband Albert, Dr. Jeremy Davidheiser, Ms. Susan Baggs, Mrs. Laurie Mele, and Director of Advancement Mrs. Kim McNulty. The English Department was in town to attend the NCTE Annual Conference in. Another highlight from the trip was lunch with alumna author Darshana Khiani ’90, who served on a panel titled “Immigrant and New Generation Children’s Literature Opens Opportunities to Integrate Race and Culture into SEL Teaching.” Darshana, a computer engineer and children’s book author, is the writer of How to Wear a Sari, I’m an American, and Building a Dream.

Rick Mikula ’68, featured in a December StandardSpeaker article, has spent decades advocating for monarch butterflies through his books, education efforts, and the Hole in Hand Butterfly Farm. Affectionately known as “The Butterfly Guy,” Rick inspires others to protect these endangered creatures by planting milkweed and preserving habitats.
Photo Credit:
Staff Photographer David McKeown

Weddings
Allesandra Ortiz ’15 married Joshua Marcacci on October 26 in Lancaster, PA.
Births
Devon Sherwood Alvarez ‘13 and her husband, Ernesto, welcomed son Aurelio on November 21. He was 6 lbs. 11oz. The family is residing in Salt Lake City, Utah.
Deaths
Abigail Paul ’18 and Dustin Paul ’22 returned to campus on January 8 to inspire future Preppers in Mr. Michael Mele’s classroom. Abigail, one of MMI’s inaugural Distinguished Young Alumni Award winners, told students about her doctoral journey in electrochemistry at Ohio University, her cutting-edge work in EV battery development using coal products, and her passion for wastewater purification. Dustin shared his experience as a West Virginia University undergrad on track to become a “landman”—the key negotiator for mineral and oil right leases.

David Caldwell passed away on December 17, 2024. He is survived by his wife, Brenda; two children, Cassie Caldwell ‘13, and David Caldwell; and two stepchildren, Jeremiah and Kendra.
Dr. Thomas Gabuzda ‘47 passed away on November 21, 2024. He is survived by his wife Stella; daughter, Dr. Dana H. Gabuzda; sons, Thomas H. Gabuzda and Paul G. Gabuzda; and granddaughter, Michelle R. Gabuzda.
John J. Yamulla Hunter ‘57 passed away on September 30, 2024. He is survived by his sister, Claudette Angelo and her husband, Richard, and several nieces and nephews.
Musician, William “Bill” Kelly passed away on December 13, 2024. Bill and his bandmate, Jerry

Hludzik ‘70 notched a Top 20 hit with the song “Timothy” and were major label contenders. Bill is survived by his wife, Anne; children, Keegan, Amber, and Jonathan; brothers, Thomas, and Michael; sister, MMI Head of School Theresa Long and husband David, and nephews Morgan Long ‘19 and Noah Long ‘21.
Joseph McCulla ‘48 passed away on December 7, 2024. He is survived by his three sons, James and his wife Susan, David and wife Lisa, and Gary and wife Christine; seven grandchildren; and 4 great grandchildren.
John Weber ‘72 passed away April 10, 2024. John is survived by his son, John, and his brother Mark Weber ‘69 and his partner Elizabeth Vanburkleo.
Morgan Allen ’21: Kutztown University (Fall 2024)
Althea Hyduke ’22: Thomas Jefferson University (Spring and Fall 2024)
Emely Lopez-Rodriguez ‘23: East Stroudsburg University (Fall 2024)
Kate Malay ‘23: Lebanon Valley College (Fall 2024)
Thomas Mayernik ‘22: Bucknell University (Fall 2024)
Kevin McNulty ’21: Rochester Institute of Technology (Fall 2024)
Manal Muhammad ’23: University of Scranton (Fall 2024)
Zachary Yenchko ‘24: Rochester Institute of Technology (Fall 2024)
Library Memorials, Annual Fund Memorials, and Honors Donated between October 31, 2024 and January 31, 2025
In Memory of Beatrice Abrams Dian, Benji, and Roxanne Abrams
In Memory of Edward Abrams ‘62 and Marlene Abrams
Mr. Richard W. Abrams ‘88
In Memory of Irving Abrams ‘30 and Lillian Abrams
Mr. Richard W. Abrams ‘88
In Memory of Jeremiah Abrams ‘65
Mr. Richard W. Abrams ‘88
In Memory of Richard Abrams ‘60 Dian, Benji, and Roxanne Abrams
In Memory of Simon Abrams ‘30 Dian, Benji, and Roxanne Abrams
In Memory of Milton and Hilda Apple
Rabbi Dr. James Apple ‘55 and Mrs. Sandra Apple
In Memory of Stanley Balon ‘38
Mr. Frank D. Balon
In Memory of Fernand Barata ‘50
Mrs. Philomena M. Barata
In Memory of Mary Ann Bellizia
Mr. Thomas Bellizia
In Memory of Louis and Alexandra Betley
Mr. Gregory Betley ‘70 and Mrs. Anne Marie Lesniak-Betley
In Honor of Paul Brasavage ‘12
Mr. and Mrs. Mark M. Brasavage
In Memory of Denis Brenan ‘55
Dr. Martin Sokoloski ‘55 and Mrs. Bonnie Sokoloski
In Memory of Lambert Broad
Mr. and Mrs. John D Kushnerick
Mr. and Mrs. Joseph G. Rudawski
In Honor of Corey Buchman ‘25
Mr. Christopher Buchman
In Memory of Kim Byriel
Ms. Julia Byriel
In Memory of David Caldwell
Mr. and Mrs. Frank P. Orlando
In Memory of Ambabai and Mahadev Chikarmane
Dr. Ajit Chikarmane and Dr. Kalpana Chikarmane
In Honor of Meghan Chikarmane ‘02
Ms. Ambika Chikarmane ‘03 and Mr. Maneesh Jain
In Honor of Dr. Sona Chikarmane ‘99
Ms. Ambika Chikarmane ‘03 and Mr. Maneesh Jain
In Memory of the deceased members of The Class of 1955
Deacon Gene Kovatch ‘55
In Honor of The Class of 1960
Mr. Ronald T. Karpowich ‘60
In Honor of The Class of 2004
Mr. Nicholas DeCandia ‘04
In Memory of Anthony J. Colangelo
Atty. Anthony Colangelo ‘78 and Mrs. Keri Lynn Colangelo
In Honor of Alexander Composto ‘25
Mr. and Mrs. Mark M. Brasavage
In Honor of Ian Composto ‘27
Mr. and Mrs. Mark M. Brasavage
In Memory of James Conahan ‘68
Dr. Thomas J. Conahan III ‘59 and Mrs. Catherine Conahan
In Memory of Thomas Conahan ‘26 and Eugenia Conahan
Dr. Thomas J. Conahan III ‘59 and Mrs. Catherine Conahan
In Memory of Bernice Correale
Senape & Associates
In Memory of Anna Crofcheck
Mr. David Bogansky and Mr. Dylan Bogansky
Dr. John Della Croce ‘73 and Mrs. Marybeth Della Croce
Mrs. Kim McNulty
Senape & Associates
In Memory of Joseph Curto ‘00
Mr. and Mrs. James Curto
In Memory of Miles Davis
Mr. Gregory Betley ‘70 and Mrs. Anne Marie Lesniak-Betley
In Memory of Edward Leon Deal ‘42
Mrs. Anne J. Frey
In Honor of Jeffrey DeAngelo ‘23
Mrs. Kathleen S. Haentjens
In Honor of Louis DeAngelo ‘21
Mrs. Kathleen S. Haentjens
In Memory of Donald DeBellas ‘69
Mrs. Ingrid DeBellas
In Memory of Francis DeBellas ‘65
Mrs. Ingrid DeBellas
In Memory of Justine Garstka
Dr. John Della Croce ‘73 and Mrs. Marybeth Della Croce
In Memory of Destinee Delregno
Dr. John Della Croce ‘73 and Mrs. Marybeth Della Croce
In Memory of Dr. Edgar L. Dessen and Mrs. Sonia Dessen
Mr. Daniel Duffy and Mrs. Beth Duffy ‘78
In Memory of Robert Edmunds ‘56
Dr. Thomas Edmunds ‘62 and Mrs. Pamela Edmunds
In Memory of Cecilia Eisenhart
Mr. Nicholas Dei Tos ‘71 and Mrs. Patricia Dei Tos
In Memory of Lawrence Fairchild
Dr. John Della Croce ‘73 and Mrs. Marybeth Della Croce
In Memory of Herr Simon Faltz
Mr. Gregory Betley ‘70 and Mrs. Anne Marie Lesniak-Betley
In Honor of Reed Floryshak ‘24
Mrs. Kathleen S. Haentjens
In Memory of Athena Ford ‘01
Mr. James Blaum and Ms. Karen Petrosky-Blaum ‘01
In Honor of Adam Frask ‘26
Mrs. Lois Zoldi
In Honor of Carter Frask ‘20
Mrs. Lois Zoldi
In Memory of Dr. Thomas Gabuzda ‘47
Dr. Thomas J. Conahan III ‘59 and Mrs. Catherine Conahan
In Memory of Mary Gallagher
The Class of 1980
In Memory of Mr. and Mrs. Stanley Garbacik
Mr. Stanley Garbacik ‘72 and Mrs. Rose Ann Garbacik
In Memory of Shirley Gaydos
Dr. John Della Croce ‘73 and Mrs. Marybeth Della Croce
In Memory of David Gicking ‘56
Mrs. Doris W. Gicking
In Memory of Robert and Linda Gicking
Mr. Jeffrey S. Gicking ‘75
In Memory of Marilyn and Morton Gordon
Mr. Scott Gordon ‘77 and Ms. Deborah Binder
In Memory of Edgar Gower
Mr. Gregory Betley ‘70 and Mrs. Anne Marie Lesniak-Betley
Mr. and Mrs. Joseph G. Rudawski
In Memory of Scott Graham ‘84
Mr. Brian Ayers and Mrs. Cynthia Ayers ‘84
In Memory of Walter D. Haentjens ‘39
Mrs. Kathleen S. Haentjens
In Memory of Thomas Hick
Mrs. Nancy Lewandowski ‘89 and Mr. James Lewandowski
In Memory of Jerry Hludzik ‘70
Dr. Vincent J. Bobby ‘75
In Memory of Catherine Hoch
Mr. Jason Cabe and Mrs. Melissa Cabe ‘96
In Memory of Earl Hoffman
Dr. John Della Croce ‘73 and Mrs. Marybeth Della Croce
In Honor of Brayden Hoover ‘29
Mr. Adam Hoover and Dr. Jennifer Moisey
Mr. Robert Moisey and Mrs. Janice Gans Moisey
In Honor of Gianna Moisey Hoover ‘23
Mr. Adam Hoover and Dr. Jennifer Moisey
Mr. Robert Moisey and Mrs. Janice Gans Moisey
In Honor of Jacob Hoover ‘27
Mr. Adam Hoover and Dr. Jennifer Moisey
Mr. Robert Moisey and Mrs. Janice Gans Moisey
In Honor of Joshua Hoover ‘25
Mr. Adam Hoover and Dr. Jennifer Moisey
Mr. Robert Moisey and Mrs. Janice Gans Moisey
In Honor of Gabe Horvath ‘26
Mrs. Kathi Flock
In Honor of Stella Horvath ‘29
Mrs. Kathi Flock
In Memory of John Yamulla Hunter
Dr. William Shergalis ‘58 and Mrs. Miki Shergalis
In Memory of Robert Jones ‘48
Mrs. Harriet Jones
In Memory of Wilmot Jones, Class of 1910
Mrs. Harriet Jones
In Memory of Wilmot Jones ‘45
Mrs. Harriet Jones
In Honor of Michael Kranyak ‘25
Mr. and Mrs. Michael A. Kranyak
In Memory of Bill Kelly
Dr. Vincent J. Bobby ‘75
Atty. Richard A. DiLiberto Jr. ‘79 and Atty. Faith DiLiberto
Barry, Marci, Morgan ‘21, and Aiden ‘25 Hosier
Dr. and Mrs. Gerard L. Kline
Tim, Kim, and Kevin ‘21 McNulty
In Memory of Harold Klemow
Mr. Jordan Klemow ‘80 and Mrs. Jennifer Klemow
In Memory of Dr. Johann Koenig
Mrs. Barbara M. Koenig
In Memory of Walter Kuharchik Sr. Senape & Associates
In Honor of Mary Kate Kupsky ‘25
Mr. Colby Vonderheid and Ms. Lori Blue
In Honor of Woobie Kupsky ‘24
Mr. Colby Vonderheid and Ms. Lori Blue
In Memory of Andrew and Helen Kushma
Mr. Edward Kushma ‘62 and Mrs. Fran Kushma
In Memory of Christine LaGana
Mr. Gregory Betley ‘70 and Mrs. Anne Marie Lesniak-Betley
In Memory of Crystal Loftus
Mr. John Hollis ‘64 and Mrs. Carol Hollis
In Memory of Arthur Long
Mr. Noah W. Long ‘21
In Memory of Rocco and Katherine Lutz
Mr. and Mrs. Edward Barna
Dr. Robert J. Lutz ‘63
In Memory of Alvan Lynn ‘55
Mrs. Patricia J. Lynn
In Memory of Carl Lynn ‘58
Mr. Joseph Schoen and Mrs. Judith Lynn Schoen
In Memory of Mildred Magic
Mr. Jason Lenko and Dr. Jodi W. Lenko ‘99
Dr. and Mrs. Michael A. Washinsky Sr.
In Honor of Mason Makowiec ‘31
Mr. and Mrs. Johnny M. Smith Sr.
In Honor of Stephanie Makowiec ‘02
Mr. and Mrs. Johnny M. Smith Sr.
In Memory of Carol Marhon
Mr. Nicholas Dei Tos ‘71 and Mrs. Patricia Dei Tos
In Memory of Daniel Marnell ‘68
Mr. Eric Marnell
In Memory of Jules Mason ‘32
Mr. and Mrs. C. Jeffrey Mason
Mr. and Mrs. David Mason
Roman-Mason Foundation
In Memory of Joseph McCulla ‘48
Mr. William Lacroix
Mr. and Mrs. Ray Talamini
In Memory of Dr. Thomas McGraw ‘52
The McGraw Family
Mr. Timothy Reeves and Mrs. Anne McGraw Reeves
In Memory of Elizabeth Milore
Dr. John Della Croce ‘73 and Mrs. Marybeth Della Croce
In Memory of Stephen Mischissin ‘48 and Mary Ann Mischissin
Dr. Matthew Kemenosh and Dr. Susan Mischissin-Kemenosh ‘83
In Honor of The MMI Faculty
Mr. Barry Hosier and Mrs. Marci Hosier
In Memory of Nicholas Nemesh
Mr. Gregory Betley ‘70 and Mrs. Anne Marie Lesniak-Betley
Mr. William P. Steward ‘72
In Memory of Bernard Osmanski
Mr. Anthony M. Osmanski ‘70
In Memory of Marie Feissner Perry
Atty. Thomas Feissner ‘81 and Mrs. Lisa Feissner
Mrs. Kim McNulty
Mr. John Sweda and Mrs. Jackie Sweda
In Memory of John Peters
Mr. Nicholas Dei Tos ‘71 and Mrs. Patricia Dei Tos
In Honor of Desiree Petrick ‘19
Mr. John R. Petrick
In Honor of Thomas Petrick ‘27
Mr. John R. Petrick
In Memory of Gerard Pierotti
Atty. Richard A. DiLiberto Jr. ‘79 and Atty. Faith DiLiberto
Mr. and Mrs. Jonathan L. Weaver
In Memory of Karen Riley
Mr. E. Edward Riley ‘61
In Honor of Jason Roberts ‘25
Mr. and Mrs. Dale Roberts
In Memory of John M. Robin ‘41
The Robin Family of Freeland, PA
In Memory of Florence Roskos
Mr. George M. Roskos III
In Honor of Mr. and Mrs. Joseph Rudawski
Ms. Katherine T. Lewandowski ‘21
In Memory of the Rudewick Family
Mr. and Mrs. James M. Biello
In Memory of Bill Rudewick
Mrs. Susan J. Rudewick
In Memory of William Rudewick ‘42 and Louise Rudewick
Mrs. Susan J. Rudewick
In Honor of Sam Schaeffer
Mr. William E. Genetti ‘80
In Memory of William G. Schaub ‘48
Mr. William M. Loftus ‘62
In Memory of Bernadette Senape
Mr. James Senape III ‘91 and Mrs. Kimberly Warner-Senape
Senape & Associates
In Honor of Dr. William A. Shergalis ‘58 and Mrs. Miki Shergalis
Mr. Michael Shergalis
In Memory of Jean Marie Shrosky
Dr. John Della Croce ‘73 and Mrs. Marybeth Della Croce
In Memory of Al and Ethel Siegelbaum
Mr. Ronald Pariser and Mrs. Carla Pariser ‘73
In Honor of Carol Silberg
Mr. Jed Silberg ‘94 and Mrs. Sharon Silberg
In Honor of Alex Smith ‘22
Mr. and Mrs. Johnny M. Smith Sr.
In Honor of Jessica Smith ‘17
Mr. Jonathan Smith and Mrs. Beatrice Russo-Smith
In Honor of John Smith ‘01
Mr. and Mrs. Johnny M. Smith Sr.
In Honor of Jonathan Smith ‘17
Mr. Jonathan Smith and Mrs. Beatrice Russo-Smith
In Memory of Andrew Stofan ‘22
Mr. and Mrs. Joseph G. Rudawski
In Memory of Harold and Millie Sugarman
Mr. Scott J. Sugarman ‘73
In Memory of Joseph Tito ‘92
Mr. and Mrs. Michael J. Sisack
Mr. and Mrs. Joseph Tito
In Memory of William Troell
Dr. John Della Croce ‘73 and Mrs. Marybeth Della Croce
In Memory of Walter W. Tunnessen Jr. MD ‘57
Mr. Robert Tunnessen
In Memory of Ronald Turri ‘62
Mr. Robert Turri ‘60 and Mrs. Marie Turri
In Memory of Dr. William Urosevich
Atty. Richard A. DiLiberto Jr. ‘79 and Atty. Faith DiLiberto
In Memory of Bill and Lois Vaughn
Mr. Jordan Klemow ‘80 and Mrs. Jennifer Klemow
In Memory of Donald Veglia
Mr. Joseph Dzurishin and Mrs. Sherri Dzurishin ‘80
In Memory of Dr. David Wagner and Mrs. Edith Wagner
Atty. David Stern and Mrs. Barbara Wagner ‘79
In Memory of Alice Walko
Dr. John Della Croce ‘73 and Mrs. Marybeth Della Croce
In Memory of Craig Wallen
Mr. Karl Wallen ‘87
In Honor of Elizabeth Wallen
Mr. Karl Wallen ‘87
In Honor of Ethan Warner ‘19
Mrs. Lois Zoldi
In Honor of Grace Warner ‘22
Mrs. Lois Zoldi
In Memory of Michael Wassel ‘51
Mr. and Mrs. Gerald Boyle
In Memory of Dr. David Yakacki ‘69
Mrs. Linda Yakacki
In Memory of Arthur Young
Dr. John Della Croce ‘73 and Mrs. Marybeth Della Croce
In Memory of Ann Yurkanin
Dr. John Della Croce ‘73 and Mrs. Marybeth Della Croce
In Memory of Barbara Zanolini
Dr. John Della Croce ‘73 and Mrs. Marybeth Della Croce
In Memory of Joseph Zavada ‘63
Mr. John J. Corrigan III ‘63 and Mrs. Nora Corrigan

